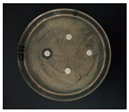
Nanomaterials 12 02636 i011

Synthesis of Eco-Friendly Silver Nanoparticles Using Glycyrrhizin and Evaluation of Their Antibacterial Ability
Abstract
:1. Introduction
2. Materials and Methods
2.1. Materials
2.2. AgNP Synthesis
2.3. AgNP Characterization
2.4. Antibacterial Activity Assay
2.5. Assessment of Cytotoxicity by MTT Assay
3. Results
3.1. Synthesis and Characterization of the Glycyrrhizin-Reduced AgNPs
3.2. Characterization of the Sodium Citrate-Reduced AgNPs
3.3. Antibacterial Activity Assay
3.4. Assessment of Cytotoxicity by MTT Assay
4. Discussion
5. Conclusions
Author Contributions
Funding
Data Availability Statement
Conflicts of Interest
References
- Parashar, V.; Parashar, R.; Sharma, B.; Pandey, A.C. Parthenium leaf extract mediated synthesis of silver nanoparticles: A novel approach towards weed utilization. Dig. J. Nanomater. Biostruct. 2009, 4, 45–50. [Google Scholar]
- RubenMorones-Ramirez, J.; Winkler, J.A.; Spina, C.S.; Collins, J.J. Silver enhances antibiotic activity against gram-negative bacteria. Sci. Transl. Med. 2013, 5, 190ra81. [Google Scholar]
- Gurunathan, S.; Jae, W.H.; Deug-Nam, K.; Jin-Hoi, K. Enhanced antibacterial and anti-biofilm activities of biosynthesized silver nanoparticles against pathogenic bacteria. J. Genet. Environ. Resour. Conserv. 2014, 9, 373. [Google Scholar]
- Zhang, H.; Li, Q.; Lu, Y.; Sun, D.; Lin, X.; Deng, X.; He, N.; Zheng, S. Biosorption and bioreduction of diamine silver complex by Corynebacterium. J. Chem. Technol. Biotechnol. 2005, 80, 285–290. [Google Scholar] [CrossRef]
- Fujisawa, Y.; Sakamoto, M.; Matsushita, M.; Fujita, T.; Nishioka, K. Glycyrrhizin inhibits the lytic pathway of complement—Possible mechanism of its anti-inflammatory effect on liver cells in viral hepatitis. Microbiol. Immunol. 2000, 44, 799–804. [Google Scholar] [CrossRef]
- Sondi, I.; Salopek-Sondi, B. Silver nanoparticles as antimicrobial agent: A case study on E. coli as a model for Gram-negative bacteria. J. Colloid Interface Sci. 2004, 275, 177–182. [Google Scholar] [CrossRef]
- Miri, S.T.; Dashti, A.; Mostaan, S.; Kazemi, F.; Bouzari, S. Identification of different Escherichia coli pathotypes in north and north-west provinces of Iran. Iran. J. Microbiol. 2017, 9, 33–37. [Google Scholar]
- Di Pinto, A.; Forte, V.T.; Ciccarese, G.; Conversano, M.C.; Tantillo, G.M. Comparison of reverse passive latex agglutination test and immunoblotting for detection of staphylococcal enterotoxin A and B. J. Food Saf. 2004, 24, 231–238. [Google Scholar] [CrossRef]
- Kluytmans, J.; Van Belkum, A.; Verbrugh, H. Nasal carriage of Staphylococcus aureus: Epidemiology, underlying mechanisms, and associated risks. Clin. Microbiol. Rev. 1997, 10, 505–520. [Google Scholar] [CrossRef]
- Babic, M.; Hujer, A.M.; Bonomo, R.A. What’s new in antibiotic resistance? Focus on beta-lactamases. Drug Resist. Update 2006, 9, 142–156. [Google Scholar] [CrossRef]
- Zhang, X.F.; Liu, Z.G.; Shen, W.; Gurunathan, S. Silver nanoparticles: Synthesis, characterization, properties, applications, and therapeutic approaches. Int. J. Mol. Sci. 2016, 17, 1534. [Google Scholar] [CrossRef]
- Njagi, E.C.; Huang, H.; Stafford, L.; Genuino, H.; Galindo, H.M.; Collins, J.B.; Hoag, G.E.; Suib, S.L. Biosynthesis of iron and silver nanoparticles at room temperature using aqueous sorghum bran extracts. Langmuir 2011, 27, 264–271. [Google Scholar] [CrossRef]
- Li, D.; Kaner, R.B. Shape and aggregation control of nanoparticles: Not shaken, not stirred. J. Am. Chem. Soc. 2006, 128, 968–975. [Google Scholar] [CrossRef]
- Lee, C.; Meisel, D. Adsorption and Surface-Enhanced Raman of Dyes on Silver and Gold Sols’. J. Phys. Chem. 1982, 60439, 3391–3395. [Google Scholar] [CrossRef]
- Erukainure, O.L.; Narainpersad, N.; Salau, V.F.; Singh, M.; Koorbanally, N.A.; Islam, S. Phytochemical constituents of sterol-rich fraction from Allium cepa L. and its cytotoxic effect on human embryonic kidney. J. Food Biochem. 2020, 45, e13586. [Google Scholar] [CrossRef]
- Mosmann, T. Rapid Colorimetric Assay for Cellular Growth and Survival: Application to Proliferation and Cytotoxicity Assays. J. Immunol. Methods 1983, 65, 55–63. [Google Scholar] [CrossRef]
- Ansari, Z.; Saha, A.; Singha, S.S.; Sen, K. Phytomediated generation of Ag, CuO and Ag-Cu nanoparticles for dimethoate sensing. J. Photochem. Photobiol. A Chem. 2018, 367, 200–211. [Google Scholar] [CrossRef]
- Iravani, S.; Zolfaghari, B. Green synthesis of silver nanoparticles using Pinus eldarica bark extract. Biomed. Res. Int. 2013, 2013, 639725. [Google Scholar] [CrossRef] [Green Version]
- Ansar, S.; Tabassum, H.; Aladwan, N.S.M.; Naiman Ali, M.; Almaarik, B.; AlMahrouqi, S.; Abudawood, M.; Banu, N.; Alsubki, R. Eco friendly silver nanoparticles synthesis by Brassica oleracea and its antibacterial, anticancer and antioxidant properties. Sci. Rep. 2020, 10, 18564. [Google Scholar] [CrossRef]
- Aghajanyan, A.; Gabrielyan, L.; Schubert, R.; Trchounian, A. Silver ion bioreduction in nanoparticles using Artemisia annua L. extract: Characterization and application as antibacterial agents. AMB Express 2020, 10, 66–69. [Google Scholar] [CrossRef]
- Bouqellah, N.A.; Mohamed, M.M.; Ibrahim, Y. Synthesis of eco-friendly silver nanoparticles using Allium sp. and their antimicrobial potential on selected vaginal bacteria. Saudi J. Biol. Sci. 2019, 26, 1789–1794. [Google Scholar] [CrossRef] [PubMed]
- Mosselhy, D.A.; El-Aziz, M.A.; Hanna, M.; Ahmed, M.A.; Husien, M.M.; Feng, Q. Comparative synthesis and antimicrobial action of silver nanoparticles and silver nitrate. J. Nanopart. Res. 2015, 17, 1–10. [Google Scholar] [CrossRef]
- Balakumaran, M.D.; Ramachandran, R.; Kalaichelvan, P.T. Exploitation of endophytic fungus, Guignardia mangiferae for extracellular synthesis of silver nanoparticles and their in vitro biological activities. Microbiol. Res. 2015, 178, 9–17. [Google Scholar] [CrossRef] [PubMed]
- Raza, M.A.; Kanwal, Z.; Rauf, A.; Sabri, A.N.; Riaz, S.; Naseem, S. Size- and shape-dependent antibacterial studies of silver nanoparticles synthesized by wet chemical routes. Nanomaterials 2016, 6, 74. [Google Scholar] [CrossRef] [Green Version]
- Yacamán, M.J.; Ascencio, J.A.; Liu, H.B.; Gardea-Torresdey, J. Structure shape and stability of nanometric sized particles. J. Vac. Sci. Technol. B Microelectron. Nanom. Struct. 2001, 19, 1091. [Google Scholar] [CrossRef]
- Abbaszadegan, A.; Nabavizadeh, M.; Gholami, A.; Aleyasin, Z.S.; Dorostkar, S.; Saliminasab, M.; Ghasemi, Y.; Hemmateenejad, B.; Sharghi, H. Positively charged imidazolium-based ionic liquid-protected silver nanoparticles: A promising disinfectant in root canal treatment. Int. Endod. J. 2015, 48, 790–800. [Google Scholar] [CrossRef]
- Mandal, D.; Kumar Dash, S.; Das, B.; Chattopadhyay, S.; Ghosh, T.; Das, D.; Roy, S. Bio-fabricated silver nanoparticles preferentially targets Gram positive depending on cell surface charge. Biomed. Pharmacother. 2016, 83, 548–558. [Google Scholar] [CrossRef]
- Kim, J.S.; Kuk, E.; Yu, K.N.; Kim, J.H.; Park, S.J.; Lee, H.J.; Kim, S.H.; Park, Y.K.; Park, Y.H.; Hwang, C.Y.; et al. Antimicrobial effects of silver nanoparticles. Nanomed. Nanotechnol. Biol. Med. 2007, 3, 95–101. [Google Scholar] [CrossRef]
- Satyavani, K.; Ramanathan, T.; Gurudeeban, S. Green synthesis of silver nanoparticles by using stem derived callus extract of bitter apple (Citrullus colocynthis). Dig. J. Nanomater. Biostruct. 2011, 6, 1019–1024. [Google Scholar]
- Roy, A.; Bulut, O.; Some, S.; Mandal, A.K.; Yilmaz, M.D. Green synthesis of silver nanoparticles: Biomolecule-nanoparticle organizations targeting antimicrobial activity. RSC Adv. 2019, 9, 2673–2702. [Google Scholar] [CrossRef] [Green Version]








| E. coli | Glycyrrhizin-Reduced AgNPs Concentrations | ||
|---|---|---|---|
| 20 μg/mL | 60 μg/mL | 100 μg/mL | |
| Oxford cup diffusion method | ![]() | ![]() | ![]() |
| Growth inhibition diameter | 10 mm | 18 mm | 22 mm |
| Filter paper diffusion method | ![]() | ![]() | ![]() |
| Growth inhibition diameter | 6 mm | 12 mm | 16 mm |
| S. aureus | Glycyrrhizin-Reduced AgNPs Concentrations | ||
|---|---|---|---|
| 20 μg/mL | 60 μg/mL | 100 μg/mL | |
| Oxford cup diffusion method | ![]() | ![]() | ![]() |
| Growth inhibition diameter | 12 mm | 16 mm | 18 mm |
| Filter paper diffusion method | ![]() | ![]() | ![]() |
| Growth inhibition diameter | 6 mm | 12 mm | 14 mm |
Publisher’s Note: MDPI stays neutral with regard to jurisdictional claims in published maps and institutional affiliations. |
© 2022 by the authors. Licensee MDPI, Basel, Switzerland. This article is an open access article distributed under the terms and conditions of the Creative Commons Attribution (CC BY) license (https://creativecommons.org/licenses/by/4.0/).
Share and Cite
Feng, D.; Zhang, R.; Zhang, M.; Fang, A.; Shi, F. Synthesis of Eco-Friendly Silver Nanoparticles Using Glycyrrhizin and Evaluation of Their Antibacterial Ability. Nanomaterials 2022, 12, 2636. https://doi.org/10.3390/nano12152636
Feng D, Zhang R, Zhang M, Fang A, Shi F. Synthesis of Eco-Friendly Silver Nanoparticles Using Glycyrrhizin and Evaluation of Their Antibacterial Ability. Nanomaterials. 2022; 12(15):2636. https://doi.org/10.3390/nano12152636
Chicago/Turabian StyleFeng, Danni, Renyin Zhang, Mengting Zhang, Ashe Fang, and Feng Shi. 2022. "Synthesis of Eco-Friendly Silver Nanoparticles Using Glycyrrhizin and Evaluation of Their Antibacterial Ability" Nanomaterials 12, no. 15: 2636. https://doi.org/10.3390/nano12152636
APA StyleFeng, D., Zhang, R., Zhang, M., Fang, A., & Shi, F. (2022). Synthesis of Eco-Friendly Silver Nanoparticles Using Glycyrrhizin and Evaluation of Their Antibacterial Ability. Nanomaterials, 12(15), 2636. https://doi.org/10.3390/nano12152636